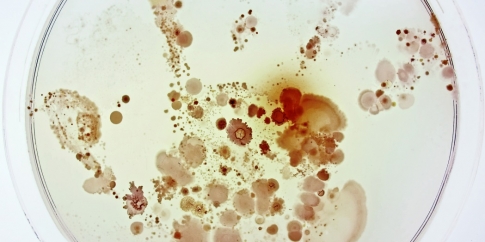

Didattica
Didattica

Museo Pietro Canonica a Villa Borghese
08/04/2018
Museo di Roma in Trastevere
01/03/2018 - 08/04/2018



Musei di Villa Torlonia
07/04/2018

Museo della Repubblica Romana e della memoria garibaldina
07/04/2018

Casa Museo Alberto Moravia
07/04/2018



** Incontro sul tema "Storia, realizzazione e diffusione dei calchi dall'antichità ai nostri giorni"
Mercati di Traiano Museo dei Fori Imperiali
06/04/2018